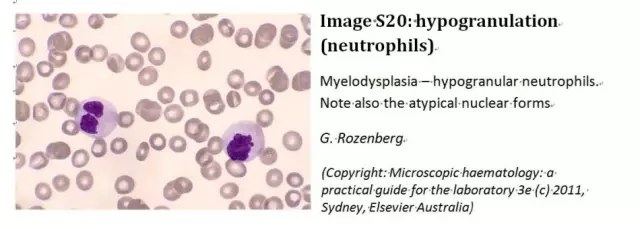
20160512095426 e4aa7
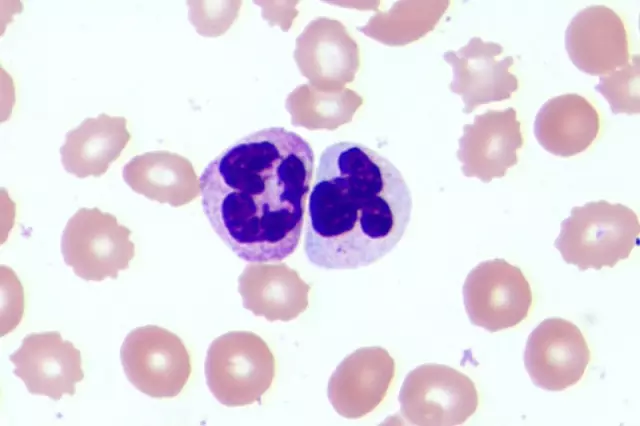
2 f4577
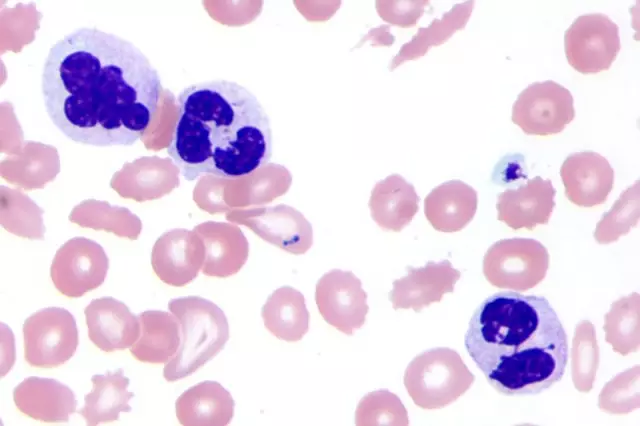
3 a1c49
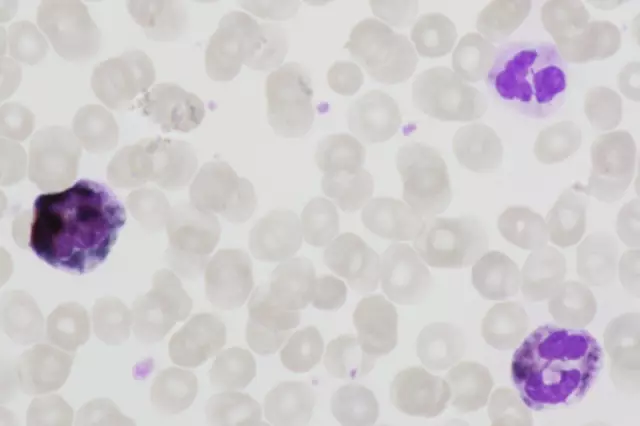
5 8d573

1.序言:在国际血液学标准委员会(ICSH)2015年发布的有关外周血细胞形态标准化命名和分级标准中,有这样一个名词:Hypogranulation – neutrophil(中性粒细胞颗粒减少),而这个细胞名称在我们以前的教材中很少提及或表述的内容。与这个细胞名词相对应的还有一个名词:Hypergranulation – neutrophil(中性粒细胞颗粒增多),或者称为toxicgranulation(中毒颗粒),本文将不讨论后一个名称和问题。
Hypogranulation – neutrophil.Supplementary image S20.
Reduced or absent neutrophilgranulation causing thecytoplasm of mature neutrophils to appearbluegrey. The recommendation is tograde hypogranulation whenseen.
译文:中性粒细胞颗粒减少,参考图S20。
中性粒细胞颗粒减少或缺如,导致中性粒细胞胞浆出现灰蓝色。见到这种现象推荐按照细胞形态标准等级报告。(图1为原文提供的参考图S20)
图1 原文参考图S20
从参考图S20中可以看到中性分叶核粒细胞胞浆内几乎未见明显的颗粒,胞浆确实呈现灰蓝色。
2.病例:最近在本院ICU病房一肺部感染病例血常规检验后复检血涂片中,发现并拍到如下图像(图2,图3),该样本中的中性粒细胞形态与ICSH推荐的中性粒细胞颗粒减少极为接近。
图2 正常中性粒细胞和中性粒细胞颗粒减少
图3 中性粒细胞颗粒减少
图2中左边的分叶核细胞胞浆内有明显的颗粒,这种颗粒被称为嗜天青颗粒;右边的分叶核细胞则几乎见不到颗粒;图3中的三个细胞几乎都见不到颗粒,或者颗粒缺如。
3.中性粒细胞颗粒:中性粒细胞内的颗粒主要包括嗜天青颗粒与特异性颗粒两类。嗜天青颗粒是在细胞的早幼粒阶段形成,是一种含有过氧化酶的、球形或椭圆形颗粒;特异性颗粒是在中幼阶段形成,不含过氧化酶。嗜天青颗粒内含有髓过氧化物酶等多种酶类和化学成分,它借助溶酶体的作用可提供给中性粒细胞,使其具有杀灭和消化功能,嗜天青颗粒还可以与活性的NADH或NADPH氧化酶产生氧化物和过氧化氢,他们一起可以对噬入的微生物起到杀灭和消化的作用。因此观察中性粒细胞的颗粒多少与是否缺失,对判断个体抵抗微生物侵袭、抗感染能力有一定意义。
4.过氧化酶染色:在某些中性粒细胞中可见到颗粒减少或缺如的情况,若经过氧化物酶染色,可以判断中性粒细胞过氧化物酶含量情况,这对细胞鉴别,疾病诊断和治疗具有临床应用价值。形态特点:中性粒细胞颗粒减少或缺如,导致中性粒细胞胞浆出现灰蓝色。经过氧化物酶染色后的血片,正常的中性粒细胞胞质内可呈现含蓝绿色或棕褐色颗粒或呈片状分布,为阳性细胞,正常情况下即大多数中性粒细胞细胞应该为阳性细胞。如仅有少许点状分布的棕褐色颗粒为弱阳性细胞,无棕褐色颗粒的为阴性细胞。从图4和图5可见到一些细胞未被染上任何颜色,也几乎见不到颗粒,这些细胞就是缺少颗粒的过氧化酶染上阴性的中性粒细胞,或者可以说是缺少颗粒的中性粒细胞。

图4 过氧化酶染色血片
图5过氧化酶染色血片
5. 过氧化酶染色价值:多用于鉴别细胞,特别是骨髓细胞类别时的一种技术手段。正常人群粒细胞呈阳性;单核细胞呈阴性或弱阳性;幼红细胞、浆细胞、巨核细胞、淋巴细胞呈阴性。
髓过氧化酶缺乏症患者中性粒细胞呈阴性或弱阳性,还可见于骨髓增生异常综合征。
6.讨论:因此是否可以说外周血的中性粒细胞颗粒减少或者缺如,有可能是髓过氧化酶减少或阴性的细胞群体。
髓过氧化酶缺乏症(myeloperoxidasedeficiency,MPO-D)是一种遗传性吞噬细胞内髓过氧化酶缺陷的免疫缺陷病,为常染色体隐性遗传,本病比较罕见。其病因与发病机制是:MPO是吞噬细胞杀菌系统中另一酶系统,PMN依赖氧以杀死细菌、真菌、病毒及肿瘤细胞的能力受依赖MPO的机制介导。本病该酶活力甚低,使中性粒细胞完全缺乏MPO-H2O2-卤化物系统的杀菌活力,而致对化脓性细菌和真菌的易感性增高。
自幼反复发生细菌和真菌感染,发生感染后不易治愈。
图2-5的病例来自重症感染患者,其外周血白细胞总数增高,中性粒细胞92%,多数中性粒细胞颗粒减少或缺如,可能是导致该患者重症,久治不愈的一个因素。
实验室检查:(1)中性粒细胞过氧化酶染色(联苯胺法)显示MPO活性降低或缺乏,尚可用流式细胞化学方法对PMN的过氧化酶活性做定量检查分析。(2)NBT还原试验和氧耗量及葡萄糖的HMP代谢正常,H2O2产生不减少。(3)还可以通过特殊原理的血细胞分析仪Adiva2120进行初筛,本病例就是作者通过观看该仪器的Perox和Baso散点图发现并镜检确认的一个病例。
Adiva2120血细胞分析仪在白细胞分类上采用过氧化酶染色法,如遇髓过氧化酶缺乏症患者,该设备不能给出白细胞的正常分类结果,但是从Perox和Baso散点图上可以发现问题和提示报警信息上可以发现异常。此类病人用其他原理的血细胞分析仪,如XE-5000,则可以正常测定和进行白细胞分类。
国内教课书中在谈到的外周血中性粒细胞异常,主要包括中毒颗粒、空泡变性、大小不等、杜勒小体等,这些都属于中性粒细胞的毒性变化,都会在严重感染、化脓性感染、中毒等病理情况下出现,但是很少谈及中性粒细胞颗粒减少或缺如的情况,以及这种现象出现的诊断价值。或许有必要在髓过氧化酶缺乏者遇到感染时,提醒临床医生在用药治疗上,应该采取与通常感染患者不同的治疗方法,或许更为对临床有帮助,起到检验医师参与临床诊断与建议的作用。此次ICSH提供的推荐意见,对我们了解这一现象,了解他的临床应用价值,会有一定帮助。或许我们在今后工作中要注意这一现象,在以后的教材与专著中提及这一现象,与最新的细胞形态学概念接轨。
有关中性粒细胞颗粒减少或缺如,他与过氧化酶染色,以及与髓过氧化酶缺乏症,与难以治愈的重症感染之间的关系,需要更多的病例和临床科研进行证实,后续应有更多的细致研究有待进行。
(内容来源于协和检验_张时民新浪博客,作者:北京协和医院检验科 张时民,转载出于传递更多信息之目的,版权和荣誉归原作者所有。如有侵权请联系我们妥善处理!)
